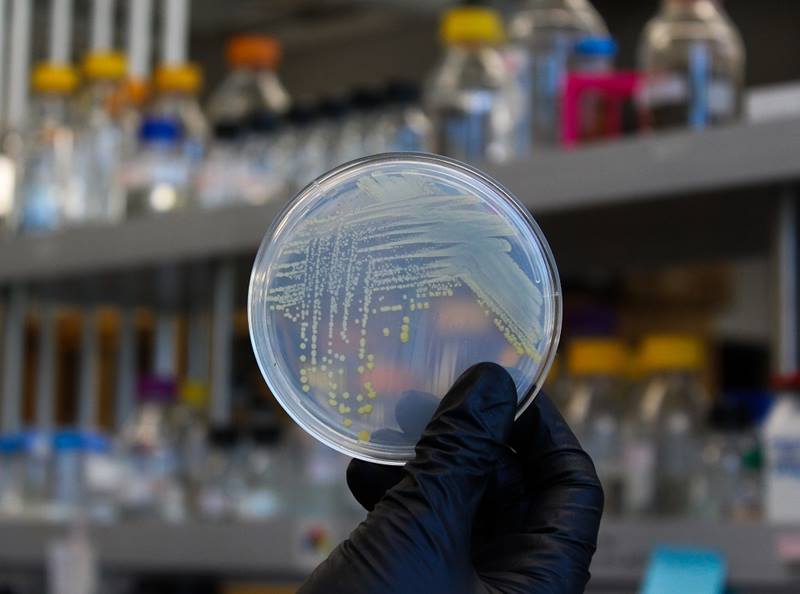
Researchers Use Vitamins to Decode Complex Interactions in the Soil Microbiome

The Science
Communities of microbes (microbiomes), particularly in soils, can be startlingly diverse, with as many as 10,000 species in just a cup of material. Scientists are working to understand how microbiomes and their members respond to their environments. These processes can profoundly shape the properties and composition of soils. In a pair of publications, researchers investigated how different species of microbes interact with one another and exchange resources such as vitamins. The studies focused on corrinoids, the vitamin B12 family of nutrients. Many bacteria in the environment cannot produce these chemicals. A deeper understanding of how microbes exchange these critical nutrients may help us understand how microbiomes control processes such as carbon and nutrient cycling.
The Impact
The Earth’s soils are critically important to maintaining ecosystem health through their ability to store organic matter, cycle nutrients, hold and filter water, and provide physical support and nutrients for plants. Microbes play an important role in these and other soil properties. This means that the ability to manipulate microbiome behavior may offer ways to improve what soils contribute. These two studies demonstrated that the presence of corrinoids can influence how individual soil bacteria grow in the laboratory and how they survive and coexist in soil. These observations open the door to developing new ways to manipulate microbiomes to promote soil health.
Summary
The complexity of microbial interactions poses a challenge for researchers aiming to understand microbiome function. Two recent studies focused on corrinoids, a key family of shared nutrients in the vitamin B12 family, to investigate how the responses of individual microbes to their environment collectively influence soil microbiome function. Focusing on a single type of nutrient enables the study of microbiomes in greater detail. The two studies further synergized by focusing on the same California grassland soil, allowing the researchers to generate a framework for understanding nutrient cycling in this system.
The first study focused on the impact of corrinoids on individual bacteria. The researchers isolated more than 100 soil bacteria, 37 of which were novel species, and tested whether they could produce corrinoids or would need to rely on others to supply corrinoids. Of these bacteria, 60% produced corrinoids, but only a few released them from the cell when cultured in the laboratory. The finding suggests that corrinoid-releasing organisms might supply these critical nutrients to other microbiome community members and have a large impact on shaping microbiome assembly and activity in the environment. The second study investigated corrinoids in soils. Chemical analysis revealed that soils contain corrinoids at levels that exceed those required for maximal microbial growth, though most are tightly bound to the soil matrix. The study further demonstrated that adding different corrinoids to soil can transiently alter the soil microbiome. This suggests that corrinoids may offer an opportunity to influence the structure and behavior of complex microbiomes in engineered and environmental systems.
Contact
Michi Taga
University of California, Berkeley
taga@berkeley.edu
Funding
This research was funded by the Department of Energy (DOE) Office of Science, Office of Biological and Environmental Research, Genomic Sciences Program and its “Microbes Persist” Soil Microbiome Scientific Focus Area. The research was also funded by the National Institutes of Health’s National Institute of General Medical Sciences, the National Graduate Degrees for Minorities in Engineering and Science (GEM) Consortium, the Kase-Tsujimoto Foundation, and the Sponsored Projects for Undergraduate Researchers program at the University of California, Berkeley.
Publications
Alvarez-Aponte, Z.I., et al., Phylogenetic distribution and experimental characterization of corrinoid production and dependence in soil bacterial isolates. The ISME Journal 18, 1, wrae068, (2024). [DOI: 10.1093/ismejo/wrae068]
Hallberg, Z.F., et al., Soil microbial community response to corrinoids is shaped by a natural reservoir of vitamin B12. The ISME Journal 18, 1, wrae094, (2024). [DOI: 10.1093/ismejo/wrae094]
Related Links
The University of California, Berkeley’s Taga Lab
Manipulating microbial communities with vitamins, University of California, Berkeley Department of Plant & Microbial Biology news